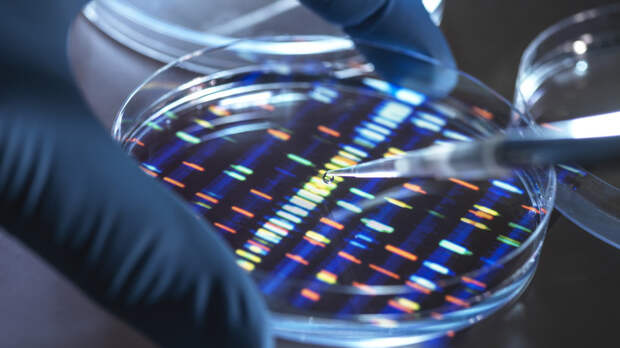

Склонность к любым типам зависимостей может быть наследственной, однако большую роль в их развитии играют факторы внешней среды. Об этом RT рассказала врач-генетик Ирина Колесникова.
«Практически все особенности организма определяются генами. Так, на молекулярном уровне запрограммирован цвет глаз, длина ступни, реакция на боль и многое другое.
То же самое касается риска развития определённых заболеваний. Например, некоторые тяжёлые патологии вроде муковисцидоза или гемофилии возникают из-за поломки всего одного гена», — подчеркнула специалист.Другие, например сахарный диабет, бронхиальная астма, ревматоидный артрит развиваются из-за комплекса факторов: образ жизни или условия внешней среды должны усилить дефектные гены, чтобы заболевание проявилось, пояснила врач-генетик Лаборатории «Гемотест».
По её словам, в случае с зависимостями работает та же схема: часть людей изначально предрасположены к их формированию, однако ничего не произойдёт без влияния среды.
«На формирование зависимости обычно влияют гены, кодирующие работу основных гормонов счастья: серотонина, дофамина и эндорфина. Например, гены ANKK1, COMT, OPRM1, DAT1. Они отвечают за вознаграждение и удовольствие, поэтому если у человека их вырабатывается много, то и эффект развивается моментально. Иными словами, люди с определёнными вариантами этих генов получают больше удовольствия от алкоголя, кофеина или никотина и меньше страдают от последствий, например, не чувствуют похмелья», — рассказала специалист.
Однако генетическая предрасположенность не означает, что человека с детства будет тянуть к алкоголю, сигаретам или азартным играм, отметила собеседница RT.
Большую роль играют и внешние факторы: это могут быть привычки членов семьи и окружения, социально-экономическое положение, травмирующие события.
Так, исследования показали, что вклад генетики в развитие алкогольной зависимости составляет до 65%. Учёные выделили целый ряд генов, ответственных за реакцию человека на спиртное.
«Например, гены ADH1B и ALDH2 отвечают за метаболизм этилового спирта в организме. К другим связанным с алкоголизмом генам учёные относят GABRA2, CHRM2, KCNJ6 и AUTS2. Если в них есть ошибки, то человек быстро пьянеет и может практически не испытывать похмелья. В комплексе с окружением или семьёй, в которых любят крепкие напитки, такое комбо может сыграть решающую роль в формировании стойкой зависимости от алкоголя», — уточнила Колесникова.
Ранее врач-терапевт Елена Попова рассказала в беседе с RT, почему именно весной у людей часто происходит обострение хронических заболеваний.
Свежие комментарии